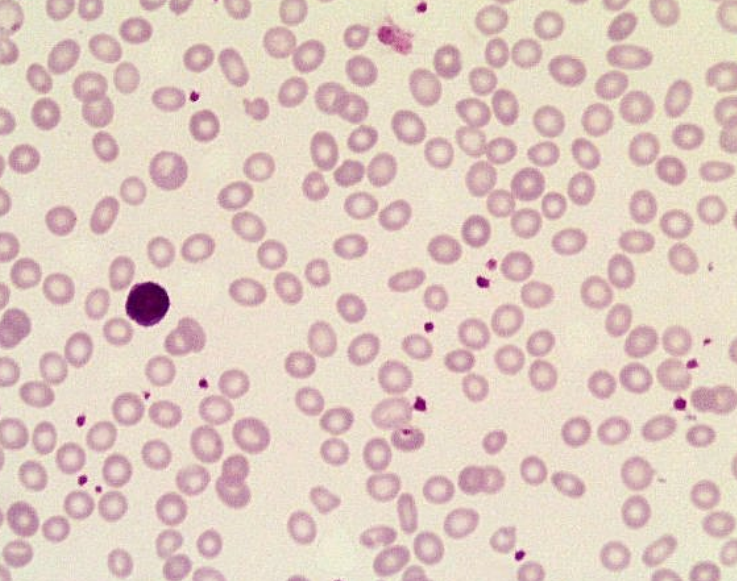

50 year old man presents with lethargy and fatigue
What causes would you consider?
Psychological
Environmental
Endocrine
Haematological
Rheumatological
CV
Respiratory
Pharmacological
Dietary
50 year old man, increasing fatigue and lethargy for 6/12
Stable weight, no regular exercise, exertional dyspnoea and palpitations, no chest pain or tightness, recent constipation and 1 episode PR bleeding, no urinary symptoms, no cough, no sputum or haemoptysis, aches and pains in large joints and back, no rash
Non-drinker, smoker (15/day and a pipe)
FHx: thalassaemia
Rx: coloxyl, occasional voltaren
SHx: works full time shift work tyre factory, lives with fellow worker, migrated from Iraq 2 years prior, wife and 2 children remain in Iraq awaiting visas, previously worked as financial consultant
O/E: slim, BP 140/75, PR 100 bpm regular, pale, clear lung fields, normal HS tachycardic, abdomen soft, no hepatosplenomegaly, no masses palpable on abdomen, PR NAD
Ix?
FBE
UEC
LFTs
Iron studies
Thyroid function
ECG
CXR
50 year old man, increasing fatigue and lethargy for 6/12
Ix: FBE demonstrates Hb 102g/L with normal WCC and Pl 480, all others normal
Possible causes classified by pathophysiology?
Blood loss: GIT, menstrual, genitourinary, chronic recurrent epistaxis, hereditary AVM
Decreased production: anaemia of chronic disease (CKD, rheumatological disorders, malignancy), bone marrow infiltration, endocrine (hypothyroidism, EPO deficiency), nutritional deficiency (B12, folate, iron), infectious causes
Increased destruction: haemolysis, sequestration in spleen
Symptoms of chronic anaemia
Decreased O2 delivery:
Exertional dyspnoea
Fatigue
Signs and symptoms of hyperdynamic circulation including bounding pulses and palpitations (worsening symptoms if underlying heart or lung disease)
Symptoms which may point to an underlying cause of anaemia
Blood loss: haematemesis, malaena, change in bowel habit, tenesmus, PR bleeding, LOW, menstrual Hx
Chronic disease or inflammation: RA, chronic infection, renal failure, thyroid disease
Dietary: vegan, vegetarian, coeliac, parasitic infection
Bone marrow failure: bleeding, infection, fevers, sweats, LOW, Hx of radiotherapy, prior malignancy
Increased destruction: dark urine, jaundice, gall stones, FHx of splenectomy, cholecystectomy
Malabsorption
Patient’s blood results demonstrate MCV 78, MCHC low
Blood film shows hypochromic microcytic red cells, increased platelet and pencil cells
What are some causes of microcytic anaemia?
Anaemia of chronic disease (normal ferritin)
Haemoglobinopathy (normal ferritin)
IDA (decreased ferritin)
What malignancies can cause decreased RBC production and therefore anaemia?
Primary bone marrow malignancy: leukaemia, lymphoma, myeloma, myeloproliferative, myelodysplastic syndromes
Secondary malignancies: breast, prostate, melanoma
What infections can cause decreased production of RBCs and therefore anaemia?
Bacterial: TB, chronic suppurative disease
Viral: HIV, HCV, CMV, EBV, parvovirus
What does a normocytic anaemia with high reticulocyte count suggest about the underlying aetiology?
Haemolysis
Blood loss
What does a normocytic anaemia with normal/low (normal would be inappropriately low) reticulocyte count suggest about the underlying aetiology?
Anaemia of chronic disease
Renal failure
Marrow failure
What are the most common causes of anaemia in the elderly?
Nutrient deficiency (e.g. IDA)
CKD and/or AKI
What are the parameters for microcytic anaemia? How does microcytic anaemia arise on a molecular level?
MCV <80
Reduced iron availability causes reduced heme synthesis and globin production
What pathological processes may result in reduced iron availability and therefore a microcytic anaemia?
Iron deficiency due to deficient diet, malabsorption, increased requirements or increased loss
Anaemia of chronic disease (causes poor utilisation of iron; e.g. in chronic infection, inflammation, cancer liver disease)
What finding is seen on peripheral smear when haem synthesis is impaired?
Basophilic stippling
What pathological processes (besides reduced iron availability) can result in reduced haem synthesis?
Lead poisoning
Acquired or congenital sideroblastic anaemia
What pathological processes (besides reduced iron availability) can result in reduced globin production?
Thalassaemias
What findings are seen on peripheral smear in thalassaemias?
Hypochromia
Microcytosis
Target cells
Tear drops
Findings on iron studies:
Ferritin 15
Serum iron 2
Transferrin 3.0
Transferrin saturation 10%
What do each of these measures indicate and what is this clinical picture?
Ferritin: iron stores, low
Serum iron: iron supply (not a very reliable indicator), low
Transferrin: iron carrier molecule
TIBC: total iron binding capacity
Transferrin saturation: serum Fe/TIBC
Clinical picture consistent with IDA
Differentiate between IDA, anaemia of chronic disease and thalassaemia in terms of expected results on iron studies parameters

Explain normal iron metabolism
Dietary iron is carried by transferrin around the body and deposited in the liver for storage, or in the bone marrow and muscle for utilisation
Loss of iron occurs through sloughing of mucosal cells, desquamation, menstruation and other blood loss (including pathological)
What are the clinical features of anaemia?
Fatigue
Pallor
Extertional dyspnoea
Koilonychia (spoon-shaped nails)
Angular cheilosis
Glossitis
The patient reports change in bowel habit with PR bleeding, as well as lethargy; remember he is also a smoker
Ix?
FOBT
Gastroscopy
Colonoscopy (Ix of choice if symptomatic)
Tumour markers
34 year old woman presents with jaundice, lethargy; previously well until flu-like illness 6/52, sore throat, 3/7 Hx of jaundice and no PMHx
Normal urine colour, no N+V, slight upper abdominal tenderness, no recent medications, bowels normal colour
No IVDU, high risk partners, transfusion Hx, overseas travel, joint pain, rash
FHx: sister with SLE, mother with hypothyroidism
Differential for jaundice and lethargy?
34 year old woman presents with jaundice, lethargy; previously well until flu-like illness 6/52, sore throat, 3/7 Hx of jaundice and no PMHx
Normal urine colour, no N+V, slight upper abdominal tenderness, no recent medications, bowels normal colour
No IVDU, high risk partners, transfusion Hx, overseas travel, joint pain, rash
O/E: pale, jaundice, tachycardia, splenomegaly, no signs of CLD or infective endocarditis, no peripheral lymphadenopathy
Ix?
FBE
LFTs
UEC
Urinalysis